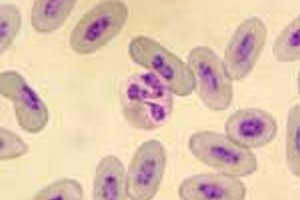
بهترین جزوات ارشد میکروب شناسی بهترین جزوات ارشد میکروب شناسی

بهترین جزوات ارشد میکروب شناسی
رتبه هفت کارشناسی ارشد میکروب شناسی مواد غذایی ازموسسه معین
درمصاحبه با روابط عمومی معین :جزوات دکتر اسماعیلی خصوصا جزوات میکروب شناسی ایشان بسیار عالی است من آنرا به داوطلبان توصیه می کنم
آذین پیرویان ، مجرد ، ساکن تهران که مدرک کارشناسی وی مهندسی کشاورزی (علوم وصنایع غذایی ) میباشد همچنین معدل کارشناسی وی 15.20 بوده که با سهمیه آزاد درآزمون وزارت بهداشت شرکت نموده در گفتگو با روابط عمومی موسسه معین راهکارهارهای موفقیت خودرا اعلام داشته است:
وی درخصوص اینکه درس انگل شناسی را بالاتر ازهمه زدند دلیل آنرا اینطور عنوان کردند که بهتر است داوطلبان به مرور وتکرار دروس مطالعه شده بپردازند، همچنین درخصوص درس بیوشیمی که پایینتر از همه زده اند دلیل آنرا کمتر وقت گذاشتن نسبت به بقیه دروس عنوان کردند ، چون پیش زمینه ای نسبت به آن نداشتند تمرکز را روی درس های دیگر قرار دادند.
آذین موفقیت خود را باتوجه به رقابت شدیدی که در این رشته وجود دارد تمرکز روی مباحث تدریس شده توسط خانم زراتی وتست زدن مداوم دانستند .
خانم پیرویان درخصوص منابع مورد استفاده خود که بیشتراز همه اثرگذاربوده وهمچنین خدماتی که از موسسه دریافت نموده خاطرنشان کرد که درک مطلبی که توسط استاد اسماعیلی تدریس شده است بسیار مثمرثمر بوده است .
آذین درخصوص محیط موسسه و برخورد پرسنل و خدمات موسسه اینگونه اظهارداشت که موسسه معین از اساتید مطرح و برجسته ای در کادر آموزشی خود بهره میبرد .
.
وی درخصوص تفاوت سوالات امسال نسبت به سال گذشته گفت کنکور امسال سخت تر از سالهای گذشته بوده است .
رتبه هفت میکروب شناسی مواد غذایی در پایان در زمینه منابع وکتابهایی که ازهمه کلیدی تر بود ودر آزمون امسال میتوانست خیلی موثر باشد اظهار داشت : جزوات دکتر اسماعیلی خصوصا جزوات میکروب شناسی ایشان بسیار عالی است من آنرا به داوطلبان توصیه می کنم .
در پایان آرزوی موفقیت برای خانم آذین پیرویان داریم .
مطالب مرتبط:
کارنامه رتبه های برتر آزمون ارشد میکروب شناسی مواد غذایی

